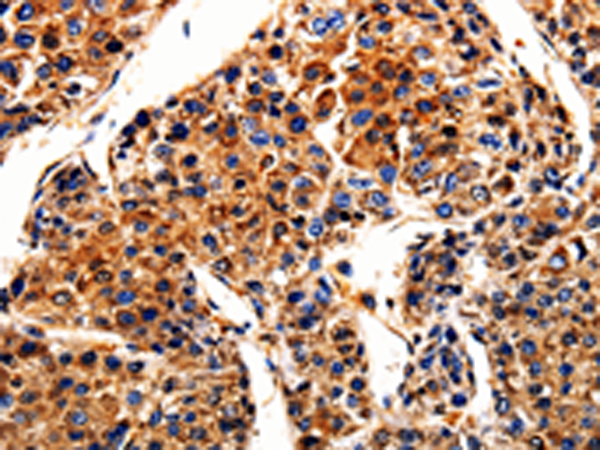

-
分类: 科研抗体货号: P06967别名: ACT, ACTG, BRWS2, DFNA20, DFNA26应用: WB反应种属: Human, Mouse, Rat
-
分类: 科研抗体货号: P06948别名: S27; MPS1; MPS-1应用: WB,IHC反应种属: Human, Mouse, Rat
-
分类: 科研抗体货号: P06985别名: APLP应用: WB,IHC反应种属: Human, Mouse
-
分类: 科研抗体货号: P06966别名: ACPP; 5'-NT; ACP-3; TM-PAP应用: WB反应种属: Human, Mouse
-
分类: 科研抗体货号: P06978别名: HOPS; TNAP; TNALP; APTNAP; TNSALP; AP-TNAP应用: IHC反应种属: Human, Mouse, Rat
-
分类: 科研抗体货号: P06984别名: AP1; AP-1; c-Jun应用: IHC反应种属: Human, Mouse, Rat
-
分类: 科研抗体货号: P06963别名: TGIFLX应用: IHC反应种属: Human
-
分类: 科研抗体货号: P06977别名: 5-LO, 5LPG, LOG5, 5-LOX应用: IHC反应种属: Human, Mouse, Rat
-
分类: 科研抗体货号: P06983别名: SNX, ANX7, SYNEXIN应用: IHC反应种属: Human, Mouse
-
分类: 科研抗体货号: P06961别名: RBM; RBM1; RBM2; RBMY; YRRM1; YRRM2; RBMY1C应用: WB反应种属: Human

鄂公网安备42018502007531号
鄂公网安备42018502007531号

